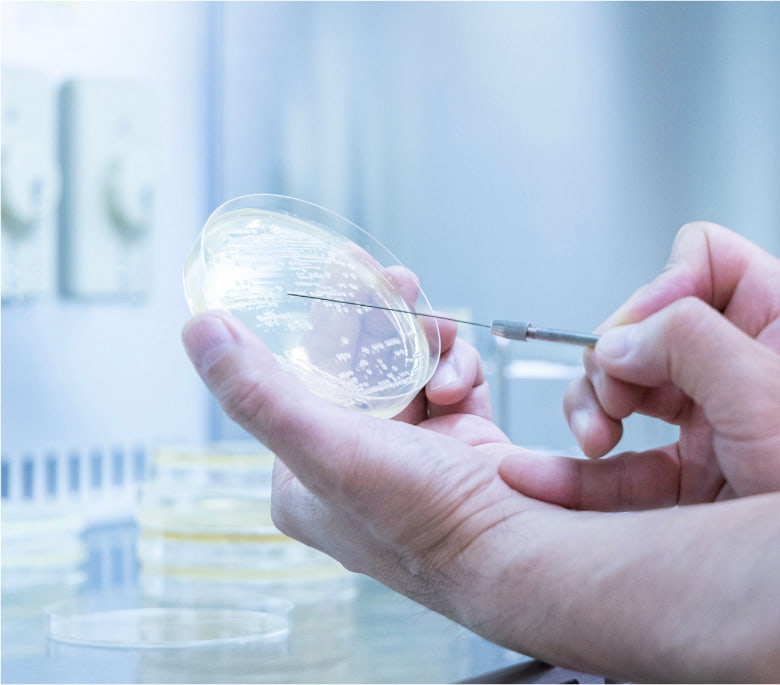

病原性を
環境~分子レベルで“斬る”
我々の周りには多くの微生物が存在します。日々の生活に有用な微生物もあれば感染症を引き起こす病原微生物も存在します。感染症は宿主動物と病原微生物の間に存在する「厳密な関係」によって引き起こされます。疾病は病原微生物によってのみ引き起されるものではなく、病原体の侵入による宿主反応の結果でもあります。病態学研究部門は感染症を「病原体側」と「宿主側」の両面から捉え、感染・発症のメカニズムを理解することを目指しています。さらに「厳密な関係」を応用した新たな疾病制御法の開発にも取り組んでいます。
主な研究内容
- バクテリオファージを応用した新規疾病制御法の開発
- 鶏大腸菌症原因菌の病原性及び薬剤耐性
- 鳥インフルエンザウイルスにおけるヒトへの感染能評価系の構築
- 野生鳥類および家禽の腸管細菌の哺乳動物感染モデルの構築
研究員
尾崎 弘一准教授/博士(獣医学)
Ozaki H, Guan Y, Peiris M, Webster R, Webby R. Changing patterns of h6 influenza viruses in Hong Kong poultry markets. Influenza Res Treat. 2011;2011:702092. doi:10.1155/2011/702092
Ozaki H, Guan Y, Peiris M, Webster R, Takada A, Webby R. Effect of the PB2 and M Genes on the Replication of H6 Influenza Virus in Chickens. Influenza Res Treat. 2014;2014:547839. doi:10.1155/2014/547839
Murase T, Ozaki H. Relationship between phylogenetic groups of Escherichia coli and Pathogenicity among Isolates from chickens with Colibacillosis and healthy chickens. Poult Sci. 2022;101(9):102007. doi:10.1016/j.psj.2022.102007
村瀬 敏之教授/博士(獣医学)
細菌感染症の分子疫学
Murase T, Ozaki H. Relationship between phylogenetic groups of Escherichia coli and Pathogenicity among Isolates from chickens with Colibacillosis and healthy chickens. Poult Sci. 2022;101(9):102007. doi:10.1016/j.psj.2022.102007
Nishikawa R, Murase T, Ozaki H. Plasmid-mediated quinolone resistance in Escherichia coli isolates from commercial broiler chickens and selection of fluoroquinolone-resistant mutants. Poult Sci. 2019;98(11):5900-5907. doi:10.3382/ps/pez337
Murase T, Nagato M, Shirota K, Katoh H, Otsuki K. Pulsed-field gel electrophoresis-based subtyping of DNA degradation-sensitive Salmonella enterica subsp. enterica serovar Livingstone and serovar Cerro isolates obtained from a chicken layer farm. Vet Microbiol. 2004;99(2):139-143. doi:10.1016/j.vetmic.2003.11.014
金井 亨輔准教授/博士(生命科学)
鳥インフルエンザウイルス株のヒト感受性評価系の構築
Kanai K, Kageyama S, Yoshie O. Involvement of TLR4 in Acute Hepatitis Associated with Airway Infection of Murine γ-Herpesvirus 68. J Immunol. 2023;211(10):1550-1560. doi:10.4049/jimmunol.2200653
Kanai K, Park AM, Watanabe A, et al. Murine γ-Herpesvirus 68 Induces Severe Lung Inflammation in IL-27-Deficient Mice with Liver Dysfunction Preventable by Oral Neomycin. J Immunol. 2018;200(8):2703-2713. doi:10.4049/jimmunol.1700412
Kanai K, Park AM, Yoshida H, Tsunoda I, Yoshie O. IL-35 Suppresses Lipopolysaccharide-Induced Airway Eosinophilia in EBI3-Deficient Mice. J Immunol. 2017;198(1):119-127. doi:10.4049/jimmunol.1600506
小幡 史子准教授/博士(理学)
Matthews MM, Kim TG, Kim KY, et al. Engineered protein subunit COVID19 vaccine is as immunogenic as nanoparticles in mouse and hamster models. Sci Rep. 2024;14(1):25528. Published 2024 Oct 26. doi:10.1038/s41598-024-76377-y
Obata F, Ozuru R, Tsuji T, Matsuba T, Fujii J. Stx2 Induces Differential Gene Expression and Disturbs Circadian Rhythm Genes in the Proximal Tubule. Toxins (Basel). 2022;14(2):69. Published 2022 Jan 19. doi:10.3390/toxins14020069
Obata F, Hippler LM, Saha P, Jandhyala DM, Latinovic OS. Shiga toxin type-2 (Stx2) induces glutamate release via phosphoinositide 3-kinase (PI3K) pathway in murine neurons. Front Mol Neurosci. 2015;8:30. Published 2015 Jul 14. doi:10.3389/fnmol.2015.00030
Obata F, Tohyama K, Bonev AD, et al. Shiga toxin 2 affects the central nervous system through receptor globotriaosylceramide localized to neurons. J Infect Dis. 2008;198(9):1398-1406. doi:10.1086/591911
柴田 敏史講師/博士(生命システム科学)
Shibata S, et al. Filamentous structures in the cell envelope are associated with bacteroidetes gliding machinery. Commun Biol. 2023 Jan 23;6(1):94. doi: 10.1038/s42003-023-04472-3. PMID: 36690840.
Shibata S, et al. Structure of polymerized type V pilin reveals assembly mechanism involving protease-mediated strand exchange. Nat Microbiol. 2020 Jun;5(6):830-837. doi: 10.1038/s41564-020-0705-1. Epub 2020 Apr 13. PMID: 32284566.
Shibata S, Matsunami H, Aizawa SI, Wolf M. Torque transmission mechanism of the curved bacterial flagellar hook revealed by cryo-EM. Nat Struct Mol Biol. 2019 Oct;26(10):941-945. doi: 10.1038/s41594-019-0301-3. Epub 2019 Sep 30. PMID: 31570877.









